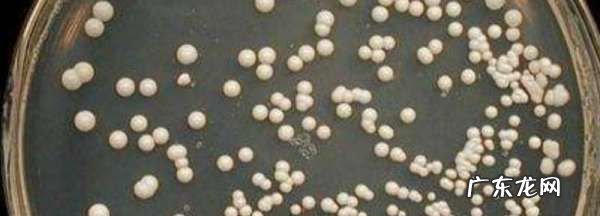

酵母是什么做的酵母是用酵母菌种发酵,培养出大量的酵母菌体,经干燥等工艺做成的 。酵母菌是一些单细胞真菌,并非系统演化分类的单元 。已知有1000多种酵母,根据酵母菌产生孢子的能力 , 可将酵母分成三类:形成孢子的株系属于子囊菌和担子菌 。不形成孢子但主要通过芽殖来繁殖的称为不完全真菌,或者叫“假酵母” 。已知大部分酵母被分类到子囊菌门 。酵母菌主要的生长环境是潮湿或液态环境,有些酵母菌也会生存在生物体内 。
文章插图
酵母是用酵母菌种发酵,培养出大量的酵母菌体,经干燥等工艺做成的 。酵母菌是一些单细胞真菌 , 并非系统演化分类的单元 。已知有1000多种酵母,根据酵母菌产生孢子(子囊孢子和担孢子)的能力,可将酵母分成三类:形成孢子的株系属于子囊菌和担子菌 。不形成孢子但主要通过芽殖来繁殖的称为不完全真菌 , 或者叫“假酵母” 。已知大部分酵母被分类到子囊菌门 。酵母菌主要的生长环境是潮湿或液态环境,有些酵母菌也会生存在生物体内 。
酵母是什么做的酵母是用酵母菌种发酵,培养出大量的酵母菌体,经干燥等工艺做成的 。
酵母是基因克隆实验中常用的真核生物受体细胞,培养酵母菌和培养大肠杆菌一样方便 。酵母是一种单细胞真菌,并非系统演化分类的单元 。
一种肉眼看不见的微小单细胞微生物 , 能将糖发酵成酒精和二氧化碳 , 分布于整个自然界 , 是一种典型的异养兼性厌氧微生物,在有氧和无氧条件下都能够存活,是一种天然发酵剂 。

文章插图
酵母粉
酵母粉 , 是一种酵母抽提物,它采用新鲜酵母为原料 , 经过生物酶解、精制、浓缩而成 。可广泛用作生物培养基和制造原料 。干酵母粉在发酵时会产生二氧化碳,以这个为原理,二氧化碳气体分布在面团的面筋里,使面筋变成如海绵状多孔的疏松体 。再经过揉面和烤制,面团里的二氧化碳受热膨胀 。
酵母是什么东西酵母是一种单细胞真菌,一种肉眼看不见的微小单细胞微生物,能将糖发酵成酒精和二氧化碳 。
酵母分布于整个自然界,它也是人类直接食用量最大的一种微生物 。其实酵母的正式称呼是酵母菌 , 它是以糖类、淀粉和其他工农业副产物为原料,用发酵培养法生产的微生物制品 。
酵母是一种单细胞微生物 。有细胞核、细胞膜、细胞壁、线粒体、相同的酶和代谢途经 。酵母无害,容易生长,空气中、土壤中、水中、动物体内都存在酵母 。有氧气或者无氧气都能生存 。
酵母菌的生殖方式分无性繁殖和有性繁殖两大类 。其中无性繁殖主要包括:芽殖,裂殖,芽裂 。而有性繁殖包括子囊孢子 。酵母可以分为三种类型,分别为单倍体型、双倍体型、单双倍体型 。

文章插图
【酵母是什么东西做成的,酵母是什么】使用酵母粉的注意事项:
1、注意外包装 。
我们在购买酵母粉时,一定要查看酵母粉的外包装 , 看看是否有漏气,因为酵母粉是活性酵母,为了保持活性,一般都是采用真空包装,如果包装漏气了,会导致酵母粉活性受损,导致酵母粉发面的效果变差 。
所以在挑选时要捏一下酵母粉的外包装 , 查看一下是否有破损的地方 , 如果包装出现偏软或是按压时,感觉酵母粉有结块或是过硬的情况,那么就不要购买了 。
2、注意温度 。
其实酵母粉的包装上已经写明了,在35度左右酵母的活性最高 。所以我们最好使用35度的温水将酵母粉溶解之后,再加入到面团中,才能让面团发酵的时间变短,并且让面团发酵达到最佳的状态 。
什么是酵母什么是酵母
你好?。?
一: 什么是酵母:
酵母的正式称呼是酵母菌 。
以糖类、淀粉和其他工农业副产物为原料,用发酵培养法生产的微生物制品 。是酵母菌的简称 。酵母是人类直接食用量最大的一种微生物 。
二: 酵母的种类:
酵母产品有几种分类方法 。以人类食用和作动物饲料的不同目的可分成食用酵母和饲料酵母 。食用酵母中又分成面包酵母、食品酵母和药用酵母等 。
面包酵母 又分压榨酵母、活性干酵母和快速活性干酵母 。
①压榨酵母:采用酿酒酵母生产的含水分70~73%的块状产品 。呈淡黄色,具有紧密的结构且易粉碎,有强的发面能力 。在4℃可保藏1个月左右 , 在0℃能保藏2~3个月 。产品最初是用板框压滤机将离心后的酵母乳压榨脱水得到的 , 因而被称为压榨酵母,俗称鲜酵母 。发面时,其用量为面粉量的1~2%,发面温度为28~30℃,发面时间随酵母用量、发面温度和面团含糖量等因素而异,一般为1~3小时 。
②活性干酵母:采用酿酒酵母生产的含水分8%左右、颗粒状、具有发面能力的干酵母产品 。采用具有耐干燥能力、发酵力稳定的醇母经培养得到鲜酵母,再经挤压成型和干燥而制成 。发酵效果与压榨酵母相近 。产品用真空或充惰性气体(如氮气或二氧化碳)的铝箔袋或金属罐包装,货架寿命为半年到1年 。与压榨酵母相比,它具有保藏期长,不需低温保藏,运输和使用方便等优点 。
③快速活性干酵母:一种新型的具有快速高效发酵力的细小颗粒状(直径小于1mm)产品 。水分含量为4~6% 。它是在活性干酵母的基础上,采用遗传工程技术获得高度耐干燥的酿酒酵母菌株 , 经特殊的营养配比和严格的增殖培养条件以及采用流化床干燥设备干燥而得 。与活性干酵母相同,采用真空或充惰气体保藏,货架寿命为1年以上 。与活性干酵母相比,颗粒较小,发酵力高,使用时不需先水化而可直接与面粉混合加水制成面团发酵,在短时间内发酵完毕即可焙烤成食品 。该产品在本世纪70年代才在市场上出现,深受消费者的欢迎 。
食品酵母 不具有发酵力的繁殖能力,供人类食用的干酵母粉或颗粒状产品 。它可通过回收啤酒厂的酵母泥、或为了人类营养的要求专门培养并干燥而得 。美国、日本及欧洲一些国家在普通的粮食制品如面包、蛋糕、饼乾和烤饼中掺入 5%左右的食用酵母粉以提高食品的营养价值 。酵母自溶物可作为肉类、果酱、汤类、乳酪、面包类食品、蔬菜及调味料的添加剂;在婴儿食品、健康食品中作为食品营养强化剂 。由酵母自溶浸出物制得的5′-核苷酸与味精配合可作为强化食品风味的添加剂(见核苷酸类调味料) 。从酵母中提取的浓缩转化酶用作方蛋夹心巧克力的液化剂 。从以乳清为原料生产的酵母中提取的乳糖酶,可用于牛奶加工以增加甜度 , 防止乳清浓缩液中乳糖的结晶 , 适应不耐乳糖症的消费者的需要 。
药用酵母 制造方法和性质与食品酵母相同 。由于它含有丰富的蛋白质、维生素和酶等生理活性物质 , 医药上将其制成酵母片如食母生片,用于治疗因不合理的饮食引起的消化不良症 。体质衰弱的人服用后能起到一定程度的调整新陈代谢机能的作用 。在酵母培养过程中,如添加一些特殊的元素制成含硒、铬等微量元素的酵母,对一些疾病具有一定的疗效 。如含硒酵母用于治疗克山病和大骨节?。?并有一定防止细胞衰老的作用;含铬酵母可用于治疗糖尿病等 。
饲料酵母 通常用假丝酵母或脆壁克鲁维酵母经培养、干燥制成 。是不具有发酵力,细胞呈死亡状态的粉末状或颗粒状产品 。它含有丰富的蛋白质(30~40%左右)、B族维生素、氨基酸等物质,广泛用作动物饲料的蛋白质补充物 。它能促进动物的生长发育,缩短饲养期,增加肉量和蛋量 , 改良肉质和提高瘦肉......>>
酵母是干什么的
真菌的一种,黄白 。我们经常发面、酿酒、制酱等都是利用酵母引起的化学变化 。也叫酵母菌或酿母菌 。
酵母菌是什么?
酵母菌是一些单细胞真菌,并非系统演化分类的单元 。酵母菌是人类文明史中被应用得最早的微生物 。可在缺氧环境中生存 。目前已知有1000多种酵母,根据酵母菌产生孢子(子囊孢子和担孢子)的能力,可将酵母分成三类:形成孢子的株系属于子囊菌和担子菌 。不形成孢子但主要通过出芽生殖来繁殖的称为不完全真菌,或者叫“假酵母”(类酵母) 。目前已知大部分酵母被分类到子囊菌门 。酵母菌在自然界分布广泛,主要生长在偏酸性的潮溼的含糖环境中,而在酿酒中,它也十分重要 。而且猫吃了还会胀大,非常的危险 。
干酵母是什么?。吭趺从茫?
a. 干酵母是发酵面团的户用发酵剂如传统的面肥 , 发酵稳定性高不易产生杂菌没有酸臭味,
使用方便直接加入面粉中使用,非常方便,买包亲手试试 , 包装上有使用方法
什么是半干酵母与干酵母和鲜酵母有什么区别?
在面点、烘焙行业的师傅和老板们都知道:要想做出风味好、使用、又简便的馒头或面包,正确使用酵母是关键 。
如今,很多用户都知道:酵母是属于食品,不是食品添加剂,因此能放心使用 。但是 , 酵母的品种也很多,不同酵母做的产品风味是不同的,例如,使用高活性干酵母,发面很稳定但在发面的风味方面稍逊一筹;而使用鲜酵母呢,其发面风味很好,但是其冷藏保存的条件太苛刻,不太方便用户使用 。有没有一种折中的方法、既能保持良好的风味又容易保存?
答案是肯定的,国内酵母龙头企业——安琪酵母股份公司近期就推出了此种产品——半干酵母 。
所谓“半干酵母”,是具有鲜酵母发酵的好风味 , 发酵力很强,适合制作冷冻面团的优点;同时,它也具有干酵母的流动性好、适合称量和长期保存的优势 。半干酵母具有鲜明的特性 。
据悉,半干酵母属于国内首创,它代表的不仅仅是一款新产品,更重要它是安琪追求满足顾客价值最大化的体现 。
据安琪酵母研发工程师卢发先生介绍,半干酵母主要以下优点:
1、可以实现远距离运输 , 方便了广大客户对酵母风味的需求 。干酵母在干燥过程中不可避免的会产生死酵母 , 这些死酵母不仅会破化面筋,还会产生异味,所以很多专业的烘焙师在选择酵母的时候首选鲜酵母,但由于受运输、仓储、气候以及运输距离影响,一些南方以及偏远地方难以购买到新鲜酵母,而半干酵母因为保质期长达一年,所以可以运输到距离工厂较远的地方,方便了客户的购买和使用 。
2、长期保存条件在-18摄氏度以下,不需要专门的保存设施 。鲜酵母一般要在0-4摄氏度冷藏保存 , 在此条件下,酵母存在代谢,然后会存在发酵活性降低问题,因此鲜酵母在此环境的保质期为45天,保质期短 。而在冷冻条件下保存,鲜酵母由于含水量大导致酵母细胞容易受到伤害,严重降低酵母活性 。市场上很多用户没有专门的冷藏冰柜,使得用户保存上有很大局限性 。而半干酵母可以在-18摄氏度条件下保存 , 可以和鲜奶油等其他冻品放在一起,方便了用户使用 。与鲜酵母相比,半干酵母保质期可以长达一年 。
3、半干酵母也方便了中间商的配送 。鲜酵母由中间商到用户的短距离运输过程中也要求在冷藏状态,稍不注意温度会上升较快,使得鲜酵母品质得不到保证 。而半干酵母由-18摄氏度到4摄氏度温度区间较大 , 即使中间商采用普通物流短时间运输 , 也不会对酵母品质产生较大影响,这样方便了中间商的配送及配送半径也可适当加大 。
4、半干酵母可以帮助用户降低使用成本 。半干酵母活细胞数高,而干酵母中含有15%左右的死酵母,因此其发酵活性更强 。与鲜酵母相比 , 半干酵母使用量只为鲜酵母0.4倍,所以可以帮用户降低成本 。
5、半干酵母适合冷冻面团制作 。干酵母死酵母较多,因此对面筋破坏较大;而鲜酵母不适合冷冻保存,所以都不很适合冷冻面团制作 。而半干酵母自生保存条件就在-18摄氏度保存,非常适合冷冻面团的制作,可以有效提高冷冻面团保质期 。
因此,半干酵母从运输、保存条件,以及使用效果上,对广大客户来讲都是一大创新,能够为顾客带来价值 。它将是未来酵母市场的一匹黑马!
安琪的酵母是用什么做的?
是用酵母和乳化剂做的 。
酵母分为鲜酵母、干酵母两种,是一种可食用的、营养丰富的单细胞微生物,营养学上把它叫做“取之不尽的营养源” 。除了蛋白质、碳水化合物、脂类以外,酵母还富含多种维生素、矿物质和酶类 。
酵母制作发面方法:
第一步,把适量的面放到盆里 。
第二步,按面粉与酵母200:1的比例取酵母,把酵母放在小碗里用温水和匀 。水温与体温差不多就可以 。
第三步,把面中间挖个洞,倒入酵母水 。用筷子把酵母水和面和在一起 。
第四步,准备温水,再倒入挖好的小洞内,用筷子和面,使面成絮状 。
第五步,用手把絮状面揉在一起,感觉面比较软后,再用力把面揉好 。揉成团状 。
第六步,把面上盖上一层纱布 , 放置在温暖的地方 , 一个小时左右 。中间可以打开看看,面粉中间有没有形成蜂窝状,如果是,那就代表面发酵好了 。
酵母属于什么类别的添加剂
面包酵母(Saccharomycescerevisiae),又称酿酒酵母或者出芽酵母 。面包酵母是与人类关系最广泛的一种酵母 , 不仅因为传统上它用于制作面包和馒头等食品及酿酒,在现代分子和细胞生物学中用作真核模式生物,其作用相当于原核的模式生物大肠杆菌 。面包酵母是发酵中最常用的生物种类 。面包酵母的细胞为球形或者卵形,直径5–10μm 。其繁殖的方法为出芽生殖 。
酿酒酵母是第一个完成基因组测序的真核生物,测序工作于1996年完成 。
酿酒酵母的基因组包含大约1200万碱基对,分成16组染色体,共有6275个基因,其中可能约有5800个真正具有功能 。据估计其基因约有23%与人类同源 。酵母基因组数据库包含有酵母基因组的详细注释(annotation),是研究真核细胞遗传学和生理学的重要工具 。另一个重要的酿酒酵母数据库由慕尼黑蛋白质序列信息中心维护 。
在酿酒酵母测序计划开始之前,人们通过传统的遗传学方法已确定了酵母中编码RNA或蛋白质的大约2600个基因 。通过对酿酒酵母的完整基因组测序,发现在12068kb的全基因组序列中有5885个编码专一性蛋白质的开放阅读框 。这意味着在酵母基因组中平均每隔2kb就存在一个编码蛋白质的基因 , 即整个基因组有72%的核苷酸顺序由开放阅读框组成 。这说明酵母基因比其它高等真核生物基因排列紧密 。如在线虫基因组中 , 平均每隔6kb存在一个编码蛋白质的基因;在人类基因组中 , 平均每隔30kb或更多的碱基才能发现一个编码蛋白质的基因 。酵母基因组的紧密性是因为基因间隔区较短与基因中内含子稀少 。酵母基因组的开放阅读框平均长度为1450bp即483个密码子 , 最长的是位于XII号染色体上的一个功能未知的开放阅读框(4910个密码子),还有极少数的开放阅读框长度超过1500个密码子 。在酵母基因组中,也有编码短蛋白的基因,例如,编码由40个氨基酸组成的细胞质膜蛋白脂质的PMP1基因 。此外 , 酵母基因组中还包含:约140个编码RNA的基因,排列在XII号染色体的长末端;40个编码SnRNA的基因,散布于16条染色体;属于43个家族的275个tRNA基因也广泛分布于基因组中 。
序列测定揭示了酵母基因组中大范围的碱基组成变化 。多数酵母染色体由不同程度的、大范围的GC丰富DNA序列和GC缺乏DNA序列镶嵌组成 。这种GC含量的变化与染色体的结构、基因的密度以及重组频率有关 。GC含量高的区域一般位于染色体臂的中部,这些区域的基因密度较高;GC含量低的区域一般靠近端粒和着丝粒 , 这些区域内基因数目较为贫乏 。Simchen等证实,酵母的遗传重组即双链断裂的相对发生率与染色体的GC丰富区相耦合,而且不同染色体的重组频率有所差别 , 较小的Ⅰ、Ⅲ、Ⅳ和Ⅸ号染色体的重组频率比整个基因组的平均重组频率高 。?
酵母基因组另一个明显的特征是含有许多DNA重复序列 , 其中一部分为完全相同的DNA序列,如rDNA与CUP1基因、Ty因子及其衍生的单一LTR序列等 。在开放阅读框或者基因的间隔区包含大量的三核苷酸重复 , 引起了人们的高度重视 。因为一部分人类遗传疾病是由三核苷酸重复数目的变化所引起的 。还有更多的DNA序列彼此间具有较高的同源性,这些DNA序列被称为遗传丰余(genetic redundancy) 。酵母多条染色体末端具有长度超过几十个kb的高度同源区 , 它们是遗传丰余的主要区域,这些区域至今仍然在发生著频繁的DNA重组过程 。遗传丰余的另一种形式是单个基因重复,其中以分散类型最为典型,另外还有一种较为少见的类型是成簇分布的基因家族 。成簇同源区(cluster homolog......>>
什么是即发干酵母?
有新鲜酵母脱水而成,呈颗粒状的干性酵母 。由于它的使用方便和易储藏性是目前最为普遍采用的一种用于制作面包馒头等的一种酵母 。
即发性干酵母经过处理,内含乳化剂 , 易溶于水,不会结块 。使用方便 。
普通的干酵母,需要先用水溶解,把颗粒弄碎 。
成本上显然有些差别 , 但是即发性干酵母巨大的销量使得成本不再有什么差别了 。
两者的发酵能力、用量没什么差别,制作面包用量为面粉的1.5%就可以 。
酵母粉的俗称是什么 。
俗称“小苏打”、“苏打粉
酵母粉是什么,在哪里能买到
酵母粉是发酵时用的,据说还可以在里面加些东西做面膜~~~一般在超市可以买到,包装上上明确写了酵母~~~
PS酵母粉和普通小超市卖的干酵母不一样,千万别当同一种东西用,干酵母是用来做蒸馒头做面包阀干的~~~如果你要的酵母粉是为了美容做面膜的或者是当营养品的,可以去药房,超市里如沃尔玛,易初莲花?。?家乐福,健康食品店也有的,当然网上也有卖的啦 。
- 活灵活现是什么生肖,欲钱买活灵活现的生肖
- 热东西放到冰箱里面有什么危害,热的东西放入冰箱有什么影响
- 西餐主食有哪些,西方的主食是什么食物
- 粽子怎么变黄,包粽子是要放一种可以让米变成黄色的那种东西叫什么
- 洋拉子是什么,洋辣子是什么虫子
- 竹凉席有没有甲醛,冰丝凉席的原材料是什么
- 网上小额贷款不还最终有什么后果,小额网贷不还后果是什么
- 网络007是什么意思,007的意思是什么
- 砂石的种类有哪些,越南砂石都是什么品种的
- 母良妻贤是什么,贤妻良母是什么意思
特别声明:本站内容均来自网友提供或互联网,仅供参考,请勿用于商业和其他非法用途。如果侵犯了您的权益请与我们联系,我们将在24小时内删除。
